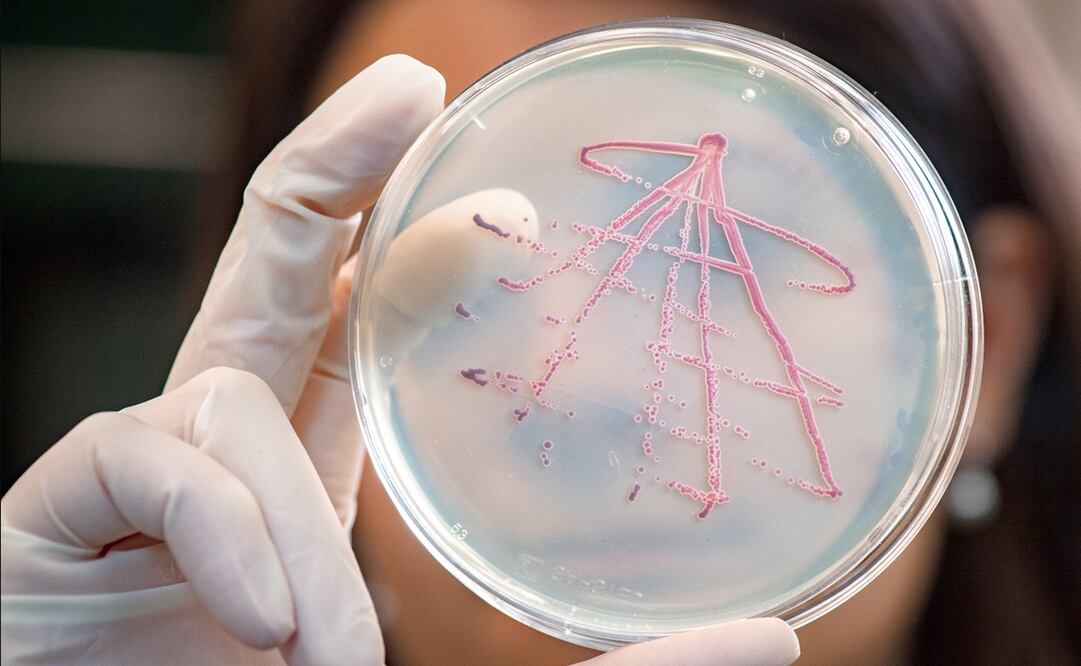
Foto: Andreas Heddergott / TUM

[Publicidad]
Un nuevo estudio ha arrojado que conforme las bacterias se van multiplicando rápidamente, también se obstaculiza su capacidad de sobrevivir.
La investigación hecha por un equipo de la Universidad Técnica de Munich ( TUM ) reveló este comportamiento de la Escherichia coli , lo cual permitiría la elaboración de antibióticos más eficaces.
“Sabemos desde hace algún tiempo que la aptitud biológica depende de dos cosas: la tasa de crecimiento cuando hay alimentos disponibles y la capacidad de sobrevivir a períodos de deficiencia de nutrientes”, dijo Ulrich Gerland , profesor de teoría de biosistemas de la casa de estudios arriba mencionada.
El Universal Responde
IA personalizada, respaldada por 109 años de historia editorial.
La observación de estas bacterias que apoyan la digestión en el intestino grueso de los mamíferos pretendía entender lo anterior, por lo que se llevó a cabo el análisis por varios años.
También lee:
Tras ello llegaron a la siguiente conclusión: "las bacterias mejor nutridad y de crecimiento más rápido son las primerar en morir cuando se les priva de alimentos", dijo.
Y es que las Escherichia coli es capaz de sobrevivir por sí misma durante periodos prolongados sin alimentarse.
También lee:
En la investigación se sometió a una dieta estricta y descubrieron que independientemente de lo bien o mal alimentados que estaban, las bacterias dejaron de reproducirse cuando se les privó de alimentos
“Aplicando el principio de la zanahoria y el palo, el crecimiento de bacterias intestinales podría estimularse al consumir un plato dulce. Esto debilitaría la bacteria si luego se administra un antibiótico contra una infección intestinal ”, explicó Garland en el comunicaddo de la TUM.
nrv
[Publicidad]
Más información

Universal Deportes
Omar Artan está decepcionado por perder "el sueño de su vida" al no ser aceptado en EU; fue interrogado durante once horas, acusa

Nación
Continúan afectaciones de tormenta tropical Boris este miércoles 10 de junio; prevén ola de calor en estos estados

Universal Deportes
Norteamérica 2026, el Mundial en el que Johan Vásquez quiere saldar deudas

Mundo
Candidato demócrata avanza hacia la elecciones primarias; supera escándalo por mensajes sexuales